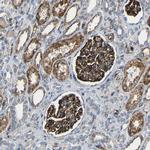
IGSF10 Antibody in Immunohistochemistry (IHC)

Search
Invitrogen
IGSF10 Polyclonal Antibody
{{$productOrderCtrl.translations['antibody.pdp.commerceCard.promotion.promotions']}}
{{$productOrderCtrl.translations['antibody.pdp.commerceCard.promotion.viewpromo']}}
{{$productOrderCtrl.translations['antibody.pdp.commerceCard.promotion.promocode']}}: {{promo.promoCode}} {{promo.promoTitle}} {{promo.promoDescription}}. {{$productOrderCtrl.translations['antibody.pdp.commerceCard.promotion.learnmore']}}

Please note: We are reviewing Western blot images included in the antibody testing data in our catalog, including those provided by third parties. Unless expressly labeled or annotated as “raw-unedited”, Western blot images included in the antibody testing data in our catalog may have been edited, optimized or otherwise adjusted for presentation.
产品信息
PA5-53009
种属反应
宿主/亚型
分类
类型
偶联物
形式
浓度
规格
纯化类型
保存液
内含物
保存条件
运输条件
RRID
产品详细信息
Immunogen sequence: AQITLPRAEM RPVKHKWTMI SRDNNTKLEH TVLVGGTVGL NCPGQGDPTP HVDWLLADGS KVRAPYVSED GRILIDKSGK LELQMADSFD TGVYHCISSN YDDADILTYR ITVVEPLVEA YQENGIHHTV FIGETLDLPC HSTGIP
Highest antigen sequence identity to the following orthologs: Mouse - 79%, Rat - 75%.
靶标信息
Ig (immunoglobulin) superfamily members exhibit functional characteristics including immune responses, growth factor signaling and cell adhesion. IGSF10 (immunoglobulin superfamily, member 10), also known as Calvaria mechanical force protein 608 (CMF608), is a 2,623 amino acid secreted protein that contains an N-terminal signal peptide, six leucine-rich repeats (LRRs), and 12 immunoglobulin-like repeats. IGSF10 exists as multiple alternatively spliced isoforms, and is expressed in bone. Specifically, expression of IGSF10 is limited to mesenchymal osteochondroprogenitors with fibroblast-like morphology, where it is thought to be involved in the maintenance of the osteochondroprogenitor cells pool and its down-regulation precedes terminal differentiation.
仅用于科研。不用于诊断过程。未经明确授权不得转售。
篇参考文献 (0)
生物信息学
蛋白别名: Calvaria mechanical force protein 608; CMF608; IgSF10; Immunoglobulin superfamily member 10
基因别名: CMF608; IGSF10
Entrez Gene ID: (Human) 285313




